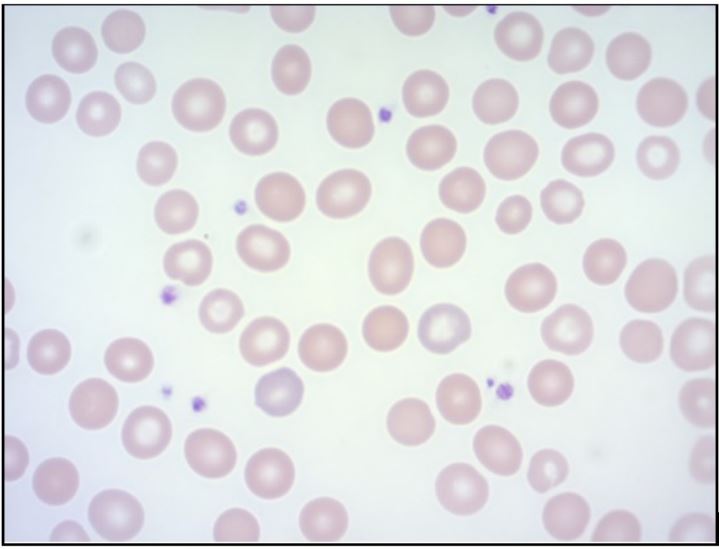
Frotis de sangre perif&eacute;rica a 100X y con tinci&oacute;n de Wright

Reporte
Anemia hemolítica desencadenada por consumo de habas en un paciente con déficit de glucosa 6 fosfato deshidrogenasa: presentación de caso en pediatría
Hemolytic anemia triggered by the consumption of faba beans in a patient with glucose-6-phosphate dehydrogenase deficiency: a pediatric case report
Anemia hemolítica desencadenada por consumo de habas en un paciente con déficit de glucosa 6 fosfato deshidrogenasa: presentación de caso en pediatría
Universitas Medica, vol. 63, núm. 4, pp. 1-7, 2022
Pontificia Universidad Javeriana
Recepción: 12 Abril 2022
Aprobación: 03 Agosto 2022
Resumen: El déficit de glucosa 6 fosfato deshidrogenasa (G6PD) es el trastorno metabólico más frecuente de los glóbulos rojos, y su presentación más común es la anemia hemolítica, que puede desencadenarse por procesos infecciosos, medicamentos o la ingesta de habas; esta última denominada favismo. Objetivo: Describir la presentación clínica del déficit de G6PD en un paciente de 3 años posterior al consumo de habas. Caso clínico: Un niño de 3 años de edad, quien presentó ictericia generalizada asociada con coliuria; consumo de habas previo al inicio de síntomas, y se sospechó favismo. Se documentó anemia moderada, hiperbilirrubinemia indirecta, elevación de lactato deshidrogenasa y frotis de sangre periférica con esferocitos y policromatofilia. Se consideró hemólisis aguda y se inició el manejo con ácido fólico. Se medió la enzima G6PD y se observó una deficiencia moderada (clase III). Conclusión: La deficiencia de G6PD es un reto diagnóstico. Con un adecuado manejo y prevención se pueden evitar casos con hemólisis severa. Es importante introducir en el tamizaje neonatal el análisis de G6PD para así lograr una disminución de morbimortalidad infantil.
Palabras clave: Reporte de caso, favismo, deficiencia de glucosa 6 fosfato deshidrogenasa, anemia hemolítica, ictericia.
Abstract: Glucose 6 phosphate dehydrogenase deficiency (G6PD) is the most common metabolic disorder of red blood cells, being hemolytic anemia its most frequent presentation which can be triggered by infectious processes, medications or the ingestion of fava beans; the latter called Favism. Objective: To describe the clinical presentation of G6PD deficiency in a child after consumption of fava beans. Clinical case:3 year old male, who presents with generalized jaundice associated with choluria, consumption of fava beans prior to the onset of symptoms, favism is suspected. Moderate anemia, indirect bilirubin increase, elevation of lactate, peripheral blood smears with spherocytes, and polychromatophilia were documented. Management with folic acid was initiated. A measurement of G6PD enzyme was performed and a moderate (class III) deficiency was confirmed. Conclusion: G6PD deficiency is a diagnostic challenge. With proper management and prevention, cases with severe hemolysis can be avoided. It is important to introduce G6PD analysis in neonatal screening in order to achieve a decrease in infant morbidity and mortality.
Keywords: Case reports, favism, glucose 6 phosphate dehydrogenase deficiency, hemolytic anemia, jaundice.
Introducción
La deficiencia enzimática de glucosa 6 fosfato deshidrogenasa (G6PD) es el trastorno metabólico más frecuente que afecta al glóbulo rojo y es la causa más común de anemia hemolítica no autoinmune de origen metabólico (1). Se estima que afecta a más de 400 millones de personas en el mundo, de las cuales aproximadamente el 11% son hombres de ascendencia africana (1,2). En el siglo XIX, pediatras de Grecia, Portugal e Italia observaron anemia severa y hemoglobinuria en niños que habían comido habas (Vicia faba) —en inglés fava beans y de ahí el término favismo (3)— y encontraron también recurrencia en las mismas personas y entre familias. Con la introducción de la primaquina, se observó que algunos pacientes presentaban reacciones de hemólisis, lo cual se denominó sensibilidad a la primaquina. Posteriormente, se determinó que el déficit de la enzima (G6PD) estaba implicado. En 1986, se secuenció el gen, el cual está localizado en la región telomérica del brazo largo del cromosoma X (Xq28), por lo que se consideró un trastorno cromosómico ligado a X (1,4,5). Esta deficiencia predispone clínicamente a la presentación de hemólisis, la cual puede ser precipitada por diferentes factores, incluyendo fiebre, enfermedades inflamatorias, consumo de habas, químicos o medicamentos, entre estos especialmente la primaquina (6).
Los glóbulos rojos son células que transportan el oxígeno de los pulmones a los tejidos y que carecen de mitocondrias, por lo cual su energía se deriva únicamente de la degradación anaeróbica de la glucosa en la vía glucolítica (7). La reducción continua de nicotinamida adenina dinucleótido fosfato (NADP+) a su forma final reducida (NADPH) es crucial para mantener altas concentraciones en los glóbulos rojos, de glutatión reducido y peroxiredoxinas, que sirven como agentes reductores en todas las acciones que involucran la reducción del peróxido y tiol. Por lo tanto, la vía de generación de NADPH es de suma importancia para la capacidad de reducción de los glóbulos rojos (figura 1). La deficiencia de G6PD hace que los glóbulos rojos presenten pocas cantidades de glutatión reducido, lo que genera mayor susceptibilidad a los fenómenos hemolíticos característicos de esta deficiencia enzimática (8).

G6PD: glucosa-6-fosfato deshidrogenasa; ATP: trifosfato de adenosina; ADP: difosfato de adenosina; NADP+: nicotinamida adenina dinucleótido fosfato (forma oxidada); NADPH: forma reducida; GSSG: glutatión oxidado; GSH: glutatión reducido.
Fuente: adaptada de (3).La prevalencia estimada para Colombia, según la Organización Mundial de la Salud (OMS), se encuentra entre el 3% y el 7% (9). Uribe encontró una prevalencia similar (10). Según las recomendaciones de la OMS, el tamizaje neonatal debe realizarse en poblaciones en las cuales la prevalencia de deficiencia de G6PD sea entre el 3% y el 5% (9). Actualmente, en Colombia no se ha instaurado un protocolo para la detección de este trastorno metabólico de los glóbulos rojos.
Caso clínico
Se presenta el caso de un niño de 3 años de edad, procedente de Bogotá (Colombia), con los siguientes antecedentes perinatales: producto de una segunda gestación, con adecuado peso y talla al nacer, adaptación neonatal espontánea y sin requerimiento de estancia en la unidad neonatal. Entre sus antecedentes familiares: sus padres eran no consanguíneos. El paciente desarrolló una hemólisis aguda por el consumo de habas (favismo). Posteriormente, se le confirmó un déficit de la enzima G6PD, con un tipo de variante clase III, que cataloga para un porcentaje de actividad residual enzimática moderada.
El niño fue llevado a urgencias por un cuadro clínico de un día de evolución, consistente en tinte ictérico en la piel y mucosas asociado con coluria, sin ninguna otra sintomatología. La madre refirió que dos días antes del inicio de los síntomas se le habían dado a comer habas, por primera vez.
En el examen físico, el niño se encontraba en buen estado general, sin signos de dificultad respiratoria, con tinte ictérico en escleras y piel, con el abdomen blando sin dolor. No se le palparon masas ni megalias, y no había otros hallazgos de importancia. Se consideró que el paciente tenía síndrome ictérico de causa no clara, y ante el antecedente de consumo de habas (Vicia faba). El juicio clínico consideró una posible hemólisis extravascular por un defecto enzimático, por lo que se iniciaron los estudios correspondientes (tabla 1), incluyendo el estudio enzimático para G6PD.

El reporte del hemograma evidenció anemia normocítica normocrómica homogénea, con un lactato deshigrogenasa aumentado y bilirrubinas con elevación a expensas de la indirecta. El extendido de sangre periférica mostró policromatófila ligera, anisocitosis ligera, presencia de macrocitos+, microcitos++ y esferocitos ocasionales (figura 2). Al paciente se le realizó una ecografía de abdomen total, donde se observó hepatomegalia; sin embargo, esta no fue palpable en el examen físico.
Nota. Se observa policromatófila ligera, anisocitosis ligera, presencia de macrocitos+, microcitos++ y esferocitos ocasionales.
Por los hallazgos anteriores, se consideró que el paciente cursaba con hemólisis moderada, sin repercusión hemodinámica. A partir de ahí, se le inició manejo con ácido fólico. Entre tanto, el reporte de la enzima G6PD estuvo en 66,7 U/L (valor de referencia 208.31 U/L), y con ello se confirmó el diagnóstico de déficit de G6PD y se clasificó, según la OMS, como un tipo de variante clase III, con un porcentaje de actividad residual enzimática moderado. Al niño se le dio egreso con medidas de educación de prevención de hemólisis en procesos infecciosos agudos y a la familia se le hizo hincapié en evitar cierto tipo de medicamentos (nitrofurantoína, antimaláricos, trimetoprima sulfametoxazol, entre otros) y evitar la ingesta de habas.
Discusión
La deficiencia enzimática de G6PD se debe a mutaciones heredadas en el gen G6PD, ubicado en el cromosoma X (Xq28). Los hombres que heredan una mutación del gen G6PD son considerados hemicigotos y serán deficientes en G6PD. Las mujeres pueden ser heterocigotas y homocigotas para la deficiencia. Las mujeres homocigotas tendrán deficiencia de G6PD; mientras que las mujeres heterocigotas tienen una combinación de células normales y deficientes en G6PD, debido a la inactivación del cromosoma X o al mosaicismo del cromosoma X (11). Las mutaciones del gen se han identificado teniendo como referencia los alelos normales (A y B) y se han detectado en la totalidad de los exones, excepto el 3 y el 13 (12). Se han identificado más de 400 mutaciones, y estas resultan en variantes de proteínas con diferentes niveles de actividad enzimática y están asociadas con una amplia gama de fenotipos bioquímicos y clínicos (1,3,12).
La primera clasificación de variantes en G6PD data de 1966, y fue actualizada por la OMS en 1985 (9). Tales variantes se clasifican en cinco clases, según el grado de deficiencia enzimática y la gravedad de la hemólisis (9,13). Las mutaciones más graves se encuentran en la clase I, caracterizada por una deficiencia enzimática grave (<10% de la actividad normal) con anemia hemolítica no esferocítica crónica y esplenomegalia. Las variantes de clase II presentan una deficiencia enzimática grave (<10% de la actividad normal) sin anemia hemolítica crónica ni esferocítica. Las variantes de clase III muestran una deficiencia enzimática de moderada a leve (10%-60% de la actividad normal) y se pueden presentar con hemólisis aguda en respuesta al estrés oxidativo. Las variantes clase IV dan como resultado una deficiencia enzimática muy leve o nula (60%-100% de la actividad normal). Finalmente, las variantes clase V se caracterizan por un aumento de más del doble en la actividad enzimática (>150% de la actividad normal) (13) (tabla 2).

La G6PD participa en el ciclo de las pentosas, y su objetivo principal es producir energía NADPH para permitir reacciones de óxido-reducción en las células del organismo. También es necesaria para regenerar la forma reducida del glutatión que se produce con una molécula de NADPH. Esto para la reducción del peróxido de hidrógeno, y los radicales de oxígeno, para el mantenimiento de la hemoglobina y otras proteínas del glóbulo rojo (1,3), que son dependientes de este ciclo para la obtención de energía. Cuando hay deficiencia de G6PD, las situaciones de estrés oxidativo hacen que las proteínas intracelulares se oxiden y agreguen para formar los corpúsculos de Heinz, lo cual le confiere una mayor rigidez al glóbulo rojo y finalmente la presentación de hemólisis (3,12).
Esta patología puede presentarse con diferentes espectros, por ejemplo, ictericia neonatal, donde la presentación más importante es el kernícterus, que consiste en daño cerebral y de los nervios auditivos por concentraciones elevadas de bilirrubina neonatal no conjugada. Entre otras presentaciones del déficit de G6PD están la anemia hemolítica aguda y la anemia hemolítica congénita crónica no esferocítica, además de que puede tener ausencia de síntomas y signos clínicos (12). La anemia hemolítica tiene un inicio desde horas a días con un promedio de hasta tres días después de haber sufrido el estrés oxidativo y no continúa a pesar de persistencia del evento desencadenante. Se cree que esto es porque los glóbulos rojos más viejos tienen mayor deficiencia de la enzima de G6PD y son más propensos a sufrir hemólisis (3). La principal causa de hemólisis son los procesos infecciosos agudos, pero es desconocido el mecanismo exacto por el cual ocurre (14). Otra causa de anemia hemolítica desencadenada por estrés oxidativo es el consumo habas, porque contienen la vicina y la convicina, que son dos glucósidos que se hidrolizan en el tubo digestivo y se convierten en divicina e isouramilo, los cuales son capaces de producir una hemólisis aguda (o lo que se conoce como favismo) (15). El consumo de habas fue el desencadenante de la anemia hemolítica en nuestro paciente y tuvo una presentación de hasta dos días después de la ingesta.
El diagnóstico definitivo del déficit de G6PD se da con la estimación de la actividad enzimática, mediante un análisis espectrofotométrico de la tasa de producción de NADPH desde NADP. Para el tamizaje rápido se han introducido métodos semicuantitativos (1), pero estas pruebas requieren experiencia para distinguir los resultados intermedios de los que indican deficiencia de G6PD (11). El diagnóstico bioquímico recomendado por la OMS se basa en la cuantificación sérica de la actividad enzimática con métodos espectrofotométricos y su consecuente clasificación según el déficit enzimático (4,5).
En el caso de nuestro paciente, se presentó una hemólisis moderada de rápida instauración luego del consumo de habas, lo que generó la sospecha inicial de favismo; posteriormente, se logró confirmar el diagnóstico midiendo la enzima G6PD, que se encontraba en 66.7 U/L, con un porcentaje de actividad residual enzimática del 32%, por lo que clasificó como una deficiencia moderada (variante clase III) (tabla 2). El principal tratamiento para la deficiencia de G6PD es evitar el estrés oxidativo. Entre otras medidas se encuentran el uso de ácido fólico una vez instaurada la hemólisis (3).
En Colombia, el tamizaje neonatal se decreta y regula mediante la Ley 1980 de 2019, donde las diferentes entidades de salud adoptan los lineamientos técnicos y operativos para su respectiva implementación progresiva, ya que ello permitirá el diagnóstico y seguimiento de siete enfermedades: hipotiroidismo congénito, fenilcetonuria, galactosemia, fibrosis quística, hiperplasia suprarrenal congénita, déficit de biotinidasa y defectos de la hemoglobina (16). Cabe mencionar que todavía no se encuentra incluida la deficiencia de G6PD dentro de esta ley. El análisis de la deficiencia de G6PD como patología cumple con los requisitos para introducirse dentro del programa de tamizaje neonatal, tiene un marcador bioquímico cuantificable, existen diversas técnicas accesibles para realizar la cuantificación y es una enfermedad potencialmente fatal con sintomatología inespecífica que puede desencadenar hemólisis leve, moderada o severa, según el déficit enzimático residual.
Conclusión
Nuestro paciente presentó una hemólisis moderada que pudo haberse evitado si se hubiese medido la enzima G6PD en el tamizaje neonatal. Consideramos que al incluir la medición de esta enzima en el tamizaje neonatal básico en Colombia, se hará una detección temprana de los casos con déficit de G6PD, para así instaurar programas de educación y prevención en relación con posibles eventos estresores oxidativos (como medicamentos o ingesta de habas). La implementación de estas medidas tendría un gran impacto en la calidad de vida de estos pacientes, al disminuir el número de consultas a urgencias, la severidad de presentación de los casos y una disminución del tiempo de estancia hospitalaria.
Conflicto de intereses
No contamos con conflictos de intereses.
Referencias
Cappellini MD, Fiorelli G. Glucose-6-phosphate dehydrogenase deficiency. Lancet. 2008;371(9606):64-74.
Nkhoma ET, Poole C, Vannappagari V, Hall SA, Beutler E. The global prevalence of glucose-6-phosphate dehydrogenase deficiency: a systematic review and meta-analysis. Blood Cells Mol Dis. 2009;42(3):267-78. https://doi.org/10.1016/j.bcmd.2008.12.005
Frank JE. Diagnosis and management of G6PD deficiency. Am Fam Phys. 2005;72(7):1277-82.
Adam A. Linkage between deficiency of glucose-6-phosphate dehydrogenase and colour-blindness. Nature. 1961;189(4765):686.
Martini G, Toniolo D, Vulliamy T, Luzzatto L, Dono R, Viglietto G, et al. Structural analysis of the X‐linked gene encoding human glucose 6‐phosphate dehydrogenase. EMBO J. 1986;5(8):1849-55. https://doi.org/10.1002/j.1460-2075.1986.tb04436.x
Spring R, Schlaack H, Rice M, Staat MA, Quinn CT. Glucose‐6‐phosphate dehydrogenase deficiency in internationally adopted children. Pediatr Blood Cancer. 2018;65(5):e26990. https://doi.org/10.1002/pbc.26990
Van Zwieten R, Verhoeven AJ, Roos D. Inborn defects in the antioxidant systems of human red blood cells. Free Rad Biol Med. 2014;67:377-86. https://doi.org/10.1016/j.freeradbiomed.2013.11.022
Beutler E. The molecular biology of G6PD variants and other red cell enzyme defects. Ann Rev Med. 1992;43(1):47-59. https://doi.org/10.1146/annurev.me.43.020192.000403
WHO Working Group. Glucose-6-phosphate dehydrogenase deficiency. WHO Bulletin OMS. 1989;67:601-11.
Uribe A. Deficiencia de glucosa 6-fosfato deshidrogenasa en Colombia: memorias de 22 años de tamizaje de alto riesgo. Revista Med. 2017;25(2):7-21.
Belfield KD, Tichy EM. Review and drug therapy implications of glucose-6-phosphate dehydrogenase deficiency. Am J Health Syst Pharm. 2018;75(3):97-104. https://doi.org/10.2146/ajhp160961
Ramírez-Cheyne J, Zarante I. Deficiencia de glucosa-6-fosfato deshidrogenasa: situación actual, su relación con malaria y estrategias para calcular su prevalencia. Univ Méd. 2009;50(1):58-76.
Lee HY, Ithnin A, Azma RZ, Othman A, Salvador A, Cheah FC. Glucose-6-phosphate dehydrogenase deficiency and neonatal hyperbilirubinemia: insights on pathophysiology, diagnosis, and gene variants in disease heterogeneity. Front Pediatr. 2022;10:875877. https://doi.org/10.3389/fped.2022.875877
Beutler E. G6PD deficiency. Blood. 1994;84(11):3613-36.
Luzzatto L, Arese P. Favism and glucose-6-phosphate dehydrogenase deficiency. N Engl J Med. 2018;378(1):60-71. https://doi.org/10.1056/nejmra1708111
Villegas JB. La ley de tamizaje neonatal en Colombia. Medicina. 2019;41(4):297-8.
Notas
Notas de autor
a Autora de correspondencia: mariac_serrano@javeriana.edu.co